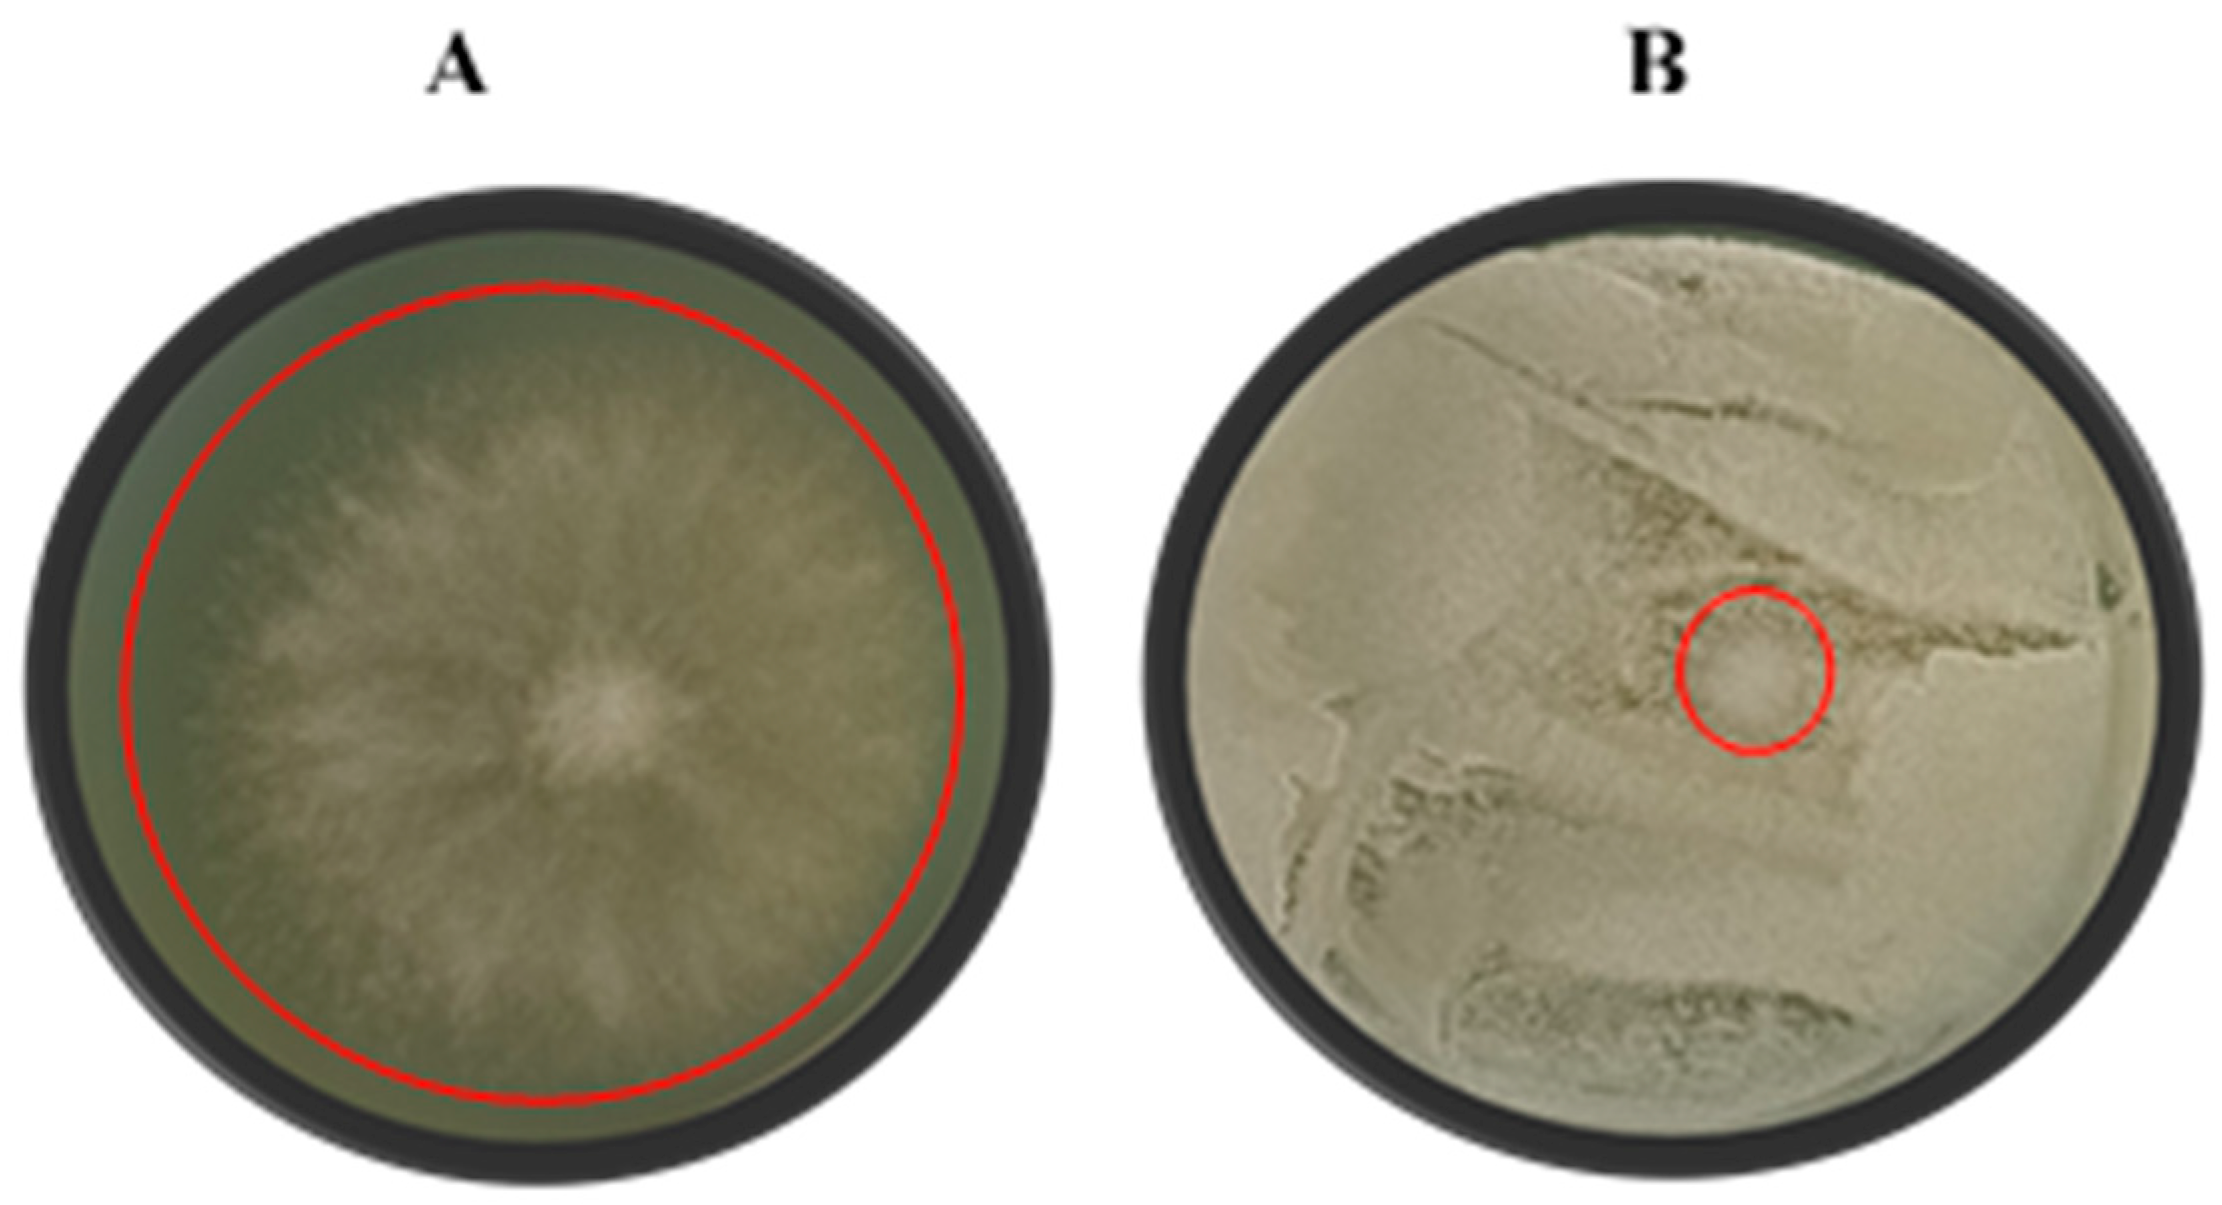
Jof 11 00026 g003

The Use of Specific Non-Saccharomyces Yeasts as Sustainable Biocontrol Solutions Against Botrytis cinerea on Apples and Strawberries
Abstract
1. Introduction
2. Materials and Methods
2.1. Culturing Conditions and Inoculum Preparation
2.2. Extracellular Lytic Enzyme Activity
2.2.1. Protease Activity
2.2.2. Chitinase Activity
2.2.3. Glucanase Activity
2.2.4. Glucosidase Activity
2.2.5. Cellulase Activity
2.2.6. Starch Degrading Activity
2.2.7. Pectinase Activity
2.2.8. Lipase Activity
2.3. Dual-Culture Assay
2.4. Mould Spore Germination Assay
2.5. Volatile Organic Compound (VOC) Production Assay
2.6. Extraction of Volatile Organic Compounds and Gas Chromatographic Analyses
2.6.1. Sample Preparation and Analyses
2.6.2. Chromatographic Conditions
2.7. Post-Harvest Fruit Bioassays
2.8. Statistical Analyses
3. Results and Discussion
3.1. Extracellular Lytic Enzymes Activity
3.2. Dual-Culture Assay
3.3. Mould Spore Germination Assay
3.4. VOC Production Assay
3.5. VOC Extraction and Gas Chromatographic Analyses
3.6. Post-Harvest Fruit Bioassays
4. Conclusions
Author Contributions
Funding
Institutional Review Board Statement
Informed Consent Statement
Data Availability Statement
Acknowledgments
Conflicts of Interest
References
- Al-Hindi, R.R.; Al-Najada, A.R.; Mohamed, S.A. Isolation and identification of some fruit spoilage fungi: Screening of plant cell wall degrading enzymes. Afr. J. Microbiol. Res. 2011, 5, 443–448. [Google Scholar]
- Abo-Elyousr, K.A.; Al-Qurashi, A.D.; Almasoudi, N.M. Evaluation of the synergy between Schwanniomyces vanrijiae and propolis in the control of Penicillium digitatum on lemons. Egyp. J. Biol. Pest Control 2021, 31, 66. [Google Scholar] [CrossRef]
- Sun, C.; Huang, Y.; Lian, S.; Saleem, M.; Li, B.; Wang, C. Improving the biocontrol efficacy of Meyerozyma guilliermondii Y-1 with melatonin against post-harvest grey mould in apple fruit. Postharvest Biol. Technol. 2021, 171, 111351. [Google Scholar] [CrossRef]
- Wang, F.; Xiao, J.; Zhang, Y.; Li, R.; Liu, L.; Deng, J. Biocontrol ability and action mechanism of Bacillus halotolerans against Botrytis cinerea causing grey mould in post-harvest strawberry fruit. Postharvest Biol. Technol. 2021, 174, 111456. [Google Scholar] [CrossRef]
- Lutz, M.C.; Lopes, C.A.; Sosa, M.C.; Sangorrin, M.P. Semi-commercial testing of regional yeasts selected from North Patagonia Argentina for the biocontrol of pear post-harvest decays. Biol. Control 2020, 150, 104246. [Google Scholar] [CrossRef]
- Guigón-López, C.; Holguín-Ibarra, P.D.; Torres-Zapien, J.H.; García-Cruz, I.; Villapando, I.; Salas-Salazar, N.A. Metarhizium anisopliae reduces conidial germination and mycelium growth of the apple grey mould Botrytis cinerea. Biol. Control 2021, 160, 104660. [Google Scholar] [CrossRef]
- Rico, D.; Barcenilla, B.; Meabe, A.; González, C.; Martín-Diana, A.B. Mechanical properties and quality parameters of chitosan-edible algae (Palmaria palmata) on ready-to-eat strawberries. J. Sci. Food Agric. 2019, 99, 2910–2921. [Google Scholar] [CrossRef] [PubMed]
- Nybom, H.; Ahmadi-Afzadi, M.; Rumpunen, K.; Tahir, I. Review of the impact of apple fruit ripening, texture and chemical contents on genetically determined susceptibility to storage rots. Plants 2020, 9, 831. [Google Scholar] [CrossRef]
- Droby, S.; Wisniewski, M.; Teixidó, N.; Spadaro, D.; Jijakli, M.H. The science, development, and commercialisation of post-harvest biocontrol products. Postharvest Biol. Technol. 2016, 122, 22–29. [Google Scholar] [CrossRef]
- Zajc, J.; Gostinčar, C.; Černoša, A.; Gunde-Cimerman, N. Stress-tolerant yeasts: Opportunistic pathogenicity versus biocontrol potential. Genes 2019, 10, 42. [Google Scholar] [CrossRef]
- Iqbal, M.; Jützeler, M.; França, S.C.; Wäckers, F.; Andreasson, E.; Stenberg, J.A. Bee-vectored Aureobasidium pullulans for biological control of grey mould in strawberry. Phytopathology 2022, 112, 232–237. [Google Scholar] [CrossRef] [PubMed]
- Kantarcioǧlu, A.S.; Yücel, A. Phospholipase and protease activities in clinical Candida isolates with reference to the sources of strains: Phospholipase-and Protease-Aktivitat bei klinischen Candida-Isolaten mit Bezug zur Herkunft der Stämme. Mycoses 2002, 45, 160–165. [Google Scholar] [CrossRef]
- Spadaro, D.; Droby, S. Development of biocontrol products for post-harvest diseases of fruit: The importance of elucidating the mechanisms of action of yeast antagonists. Food Sci. Technol. 2016, 47, 39–49. [Google Scholar] [CrossRef]
- Contarino, R.; Brighina, S.; Fallico, B.; Cirvilleri, G.; Parafati, L.; Restuccia, C. Volatile organic compounds (VOCs) produced by biocontrol yeasts. Food Microbiol. 2019, 82, 70–74. [Google Scholar] [CrossRef]
- Huang, Y.; Gao, L.; Lin, M.; Yu, T. Post-harvest Biology and Technology Recombinant expression of antimicrobial peptides in Pichia pastoris: A strategy to inhibit the Penicillium expansum in pears. Postharvest Biol. Technol. 2021, 171, 111298. [Google Scholar] [CrossRef]
- Zou, X.; Wei, Y.; Dai, K.; Xu, F.; Wang, H.; Shao, X. Yeasts from intertidal zone marine sediment demonstrate antagonistic activities against Botrytis cinerea in vitro and in strawberry fruit. Biol. Control 2021, 158, 104612. [Google Scholar] [CrossRef]
- Gomomo, Z.; Fanadzo, M.; Mewa-Ngongang, M.; Hoff, J.; Van der Rijst, M.; Okudoh, V.; Kriel, J.; du Plessis, H.W. Control of mould spoilage on apples using yeasts as biological control agents. Pol. J. Food Nutr. Sci. 2022, 72, 119–128. [Google Scholar] [CrossRef]
- Wisniewski, M.; Droby, S.; Norelli, J.; Liu, J.; Schena, L. Alternative management technologies for postharvest disease control: The journey from simplicity to complexity. Postharvest Biol. Technol. 2016, 122, 3–10. [Google Scholar] [CrossRef]
- Cordero-Bueso, G.; Mangieri, N.; Maghradze, D.; Foschino, R.; Valdetara, F.; Cantoral, J.M.; Vigentini, I. Wild grape-associated yeasts as promising biocontrol agents against Vitis vinifera fungal pathogens. Front. Microbiol. 2017, 8, 2025. [Google Scholar] [CrossRef] [PubMed]
- Mewa-Ngongang, M.; du Plessis, H.W.; Ntwampe, S.K.O.; Chidi, B.S.; Hutchinson, U.F.; Mekuto, L.; Jolly, N.P. The use of Candida pyralidae and Pichia kluyveri to control spoilage microorganisms of raw fruits used for beverage production. Foods 2019, 8, 454. [Google Scholar] [CrossRef] [PubMed]
- Al-Maawali, S.S.; Al-Sadi, A.M.; Ali Khalifa Alsheriqi, S.; Nasser Al-Sabahi, J.; Velazhahan, R. The potential of antagonistic yeasts and bacteria from tomato phyllosphere and fructoplane in the control of Alternaria fruit rot of tomato. All Life 2021, 14, 34–48. [Google Scholar] [CrossRef]
- Liu, Y.; Yao, S.; Deng, L.; Min, J.; Zeng, K. Different mechanisms of action of isolated epiphytic yeasts against Penicillium digitatum and Penicillium italicum on citrus fruit. Postharvest Biol. Technol. 2019, 152, 100–110. [Google Scholar] [CrossRef]
- Verma, K.; Garg, N. Detection of Chitinase on Chitin Agar Plates. Int. J. Sci. Res. 2019, 8, 1186–1189. [Google Scholar]
- Strauss, M.L.A.; Jolly, N.P.; Lambrecht, M.G.; Van Rensburg, P. Screening for the production of extracellular hydrolytic enzymes by non-Saccharomyces wine yeasts. J. Appl. Microbiol. 2001, 91, 182–190. [Google Scholar] [CrossRef] [PubMed]
- Buzzini, P.; Martini, A. Extracellular enzymatic activity profiles in yeast and yeast-like strains isolated from tropical environments. J. Appl. Microbiol. 2002, 93, 1020–1025. [Google Scholar] [CrossRef]
- McKay, A.M. A plate assay method for the detection of fungal polygalacturonase secretion. FEMS Microbiol. Lett. 1988, 56, 355–358. [Google Scholar] [CrossRef]
- Chen, P.H.; Chen, R.Y.; Chou, J.Y. Screening and evaluation of yeast antagonists for biological control of Botrytis cinerea on strawberry fruits. Mycobiology 2018, 46, 33–46. [Google Scholar] [CrossRef]
- Mewa-Ngongang, M.; Du Plessis, H.W.; Hlangwani, E.; Ntwampe, S.K.; Chidi, B.S.; Hutchinson, U.F.; Jolly, P. Activity interactions of crude biopreservatives against spoilage yeast consortia. Ferment 2019, 5, 53. [Google Scholar] [CrossRef]
- Núñez, F.; Lara, M.S.; Peromingo, B.; Delgado, J.; Sánchez-Montero, L.; Andrade, M.J. Selection and evaluation of Debaryomyces hansenii isolates as potential bioprotective agents against toxigenic penicillia in dry-fermented sausages. Food Microbiol. 2015, 46, 114–120. [Google Scholar] [CrossRef]
- Medina-Córdova, N.; López-Aguilar, R.; Ascencio, F.; Castellanos, T.; Campa-Córdova, A.I.; Angulo, C. Biocontrol activity of the marine yeast Debaryomyces hansenii against phytopathogenic fungi and its ability to inhibit mycotoxins production in maize grain (Zea mays L.). Biol. Control 2016, 97, 70–79. [Google Scholar] [CrossRef]
- Maluleke, E.; Jolly, N.P.; Patterton, H.G.; Setati, M.E. Antifungal activity of non-conventional yeasts against Botrytis cinerea and non-Botrytis grape bunch rot fungi. Front. Microbiol. 2022, 13, 986229. [Google Scholar] [CrossRef]
- Parafati, L.; Vitale, A.; Restuccia, C.; Cirvilleri, G. Biocontrol ability and action mechanism of food-isolated yeast strains against Botrytis cinerea causing post-harvest bunch rot of table grape. Food Microbiol. 2015, 47, 85–92. [Google Scholar] [CrossRef] [PubMed]
- Di Francesco, A.; Di Foggia, M.; Zajc, J.; Gunde-Cimerman, N.; Baraldi, E. Study of the efficacy of Aureobasidium strains belonging to three different species: A. pullulans, A. subglaciale and A. melanogenum against Botrytis cinerea of tomato. Ann. Appl. Biol. 2020, 177, 266–275. [Google Scholar] [CrossRef]
- Moura, V.S.; Pollettini, F.L.; Ferraz, L.P.; Mazzi, M.V.; Kupper, K.C. Purification of a killer toxin from Aureobasidium pullulans for the biocontrol of phytopathogens. J. Basic Microbiol. 2021, 61, 77–87. [Google Scholar] [CrossRef]
- Oksuz, S.; Sahin, I.; Yildirim, M.; Gulcan, A.; Yavuz, T.; Kaya, D.; Koc, A.N. Phospholipase and proteinase activities in different Candida species isolated from anatomically distinct sites of healthy adults. Jpn. J. Infect. Dis. 2007, 60, 280. [Google Scholar] [CrossRef]
- Mehlomakulu, N.N.; Setati, M.E.; Divol, B. Characterization of novel killer toxins secreted by wine-related non-Saccharomyces yeasts and their action on Brettanomyces spp. Int. J. Food Microbiol. 2014, 188, 83–91. [Google Scholar] [CrossRef] [PubMed]
- de Souza Ramos, L.; Barbedo, L.S.; Braga-Silva, L.A.; dos Santos, A.L.S.; Pinto, M.R.; da Graça Sgarbi, D.B. Protease and phospholipase activities of Candida spp. isolated from cutaneous candidiasis. Rev. Iberoam. Micol. 2015, 32, 122–125. [Google Scholar] [CrossRef] [PubMed]
- Yang, M.; Solis, N.V.; Marshall, M.; Garleb, R.; Zhou, T.; Wang, D.; Swidergall, M.; Pearlman, E.; Filler, S.G.; Liu, H. Control of β-glucan exposure by the endo-1, 3-glucanase Eng1 in Candida albicans modulates virulence. PLoS Pathog. 2022, 18, 1010192. [Google Scholar] [CrossRef]
- Ruas, F.A.D.; Barboza, N.R.; Castro-Borges, W.; Guerra-Sá, R. Manganese alters expression of proteins involved in the oxidative stress of Meyerozyma guilliermondii. J. Proteom. 2019, 196, 173–188. [Google Scholar] [CrossRef]
- Agirman, B.; Erten, H. Biocontrol ability and action mechanisms of Aureobasidium pullulans GE17 and Meyerozyma guilliermondii KL3 against Penicillium digitatum DSM2750 and Penicillium expansum DSM62841 causing post-harvest diseases. Yeast 2020, 37, 437–448. [Google Scholar] [CrossRef] [PubMed]
- Lorrine, O.E.; Rahman, R.N.Z.R.A.; Tan, J.S.; Khairuddin, R.F.R.; Salleh, A.B.; Oslan, S.N. Determination of Putative Vacuolar Proteases, PEP4 and PRB1 in a Novel Yeast Expression Host Meyerozyma guilliermondii strain SO using bioinformatics tools. Pertanika J. Sci. Technol. 2022, 30, 777–797. [Google Scholar] [CrossRef]
- Wang, X.; Glawe, D.A.; Kramer, E.; Weller, D.; Okubara, P.A. Biological control of Botrytis cinerea: Interactions with native vineyard yeasts from Washington State. Phytopathology 2018, 108, 691–701. [Google Scholar] [CrossRef]
- Cheng, L.; Zhou, L.; Li, D.; Gao, Z.; Teng, J.; Nie, X.; Guo, F.; Wang, C.; Wang, X.; Li, S.; et al. Combining the biocontrol agent Meyerozyma guilliermondii with UV-C treatment to manage postharvest grey mould on kiwifruit. Biol. Control 2023, 180, 105198. [Google Scholar] [CrossRef]
- Sepúlveda, X.; Vargas, M.; Vero, S.; Zapata, N. Indigenous yeasts for the biocontrol of Botrytis cinerea on table grapes in Chile. J. Fungi 2023, 9, 557. [Google Scholar] [CrossRef] [PubMed]
- Mewa Ngongang, M.; Du Plessis, H.W.; Boredi, C.S.; Hutchinson, U.F.; Ntwampe, K.S.; Okudoh, V.I.; Jolly, N.P. Physiological and antagonistic properties of Pichia kluyveri for curative and preventive treatments against post-harvest fruit fungi. Pol. J. Food Nutr. Sci. 2021, 71, 245–253. [Google Scholar] [CrossRef]
- Carbó, A.; Teixidó, N.; Usall, J.; Torres, R. Verifying the biocontrol activity of novel film-forming formulations of Candida sake CPA-1: Resilience in relation to environmental factors, rainfall episodes, and control of Botrytis cinerea on different hosts. J. Sci. Food Agric. 2019, 99, 4969–4976. [Google Scholar] [CrossRef]
- Gao, Z.; Zhang, R.; Xiong, B. Management of postharvest diseases of kiwifruit with a combination of the biocontrol yeast Candida oleophila and an oligogalacturonide. Biol. Control 2021, 156, 104549. [Google Scholar] [CrossRef]
- Nägeli, L.; Schuler, M.; Segessemann, T.; Frei, D.; Frey, J.E.; Wolfe, K.H.; Ahrens, C.H.; Freimoser, F.M. Genome sequence data of the strongly antagonistic yeast Pichia kluyveri isolate APC 11.10 B as a foundation for analysing biocontrol mechanisms. Data Brief 2023, 49, 109394. [Google Scholar] [CrossRef] [PubMed]
- Choińska, R.; Piasecka-Jóźwiak, K.; Chabłowska, B.; Dumka, J.; Łukaszewicz, A. Biocontrol ability and volatile organic compounds production as a putative mode of action of yeast strains isolated from organic grapes and rye grains. Anton Leeuw. 2020, 113, 1135–1146. [Google Scholar] [CrossRef] [PubMed]
- Li, Z.; Liu, Q.; Wu, C.; Yuan, Y.; Ni, X.; Wu, T.; Chang, R.; Wang, Y. Volatile organic compounds produced by Metschnikowia pulcherrima yeast T-2 inhibited the growth of Botrytis cinerea in post-harvest blueberry fruits. Hort Plant. J. 2024. [Google Scholar] [CrossRef]
- Zou, X.; Wei, Y.; Zhu, J.; Sun, J.; Shao, X. Volatile organic compounds of Scheffersomyces spartinae W9 have antifungal effect against Botrytis cinerea on strawberry fruit. Foods 2023, 12, 3619. [Google Scholar] [CrossRef] [PubMed]
- Ruiz-Moyano, S.; Hernández, A.; Galvan, A.I.; Córdoba, M.G.; Casquete, R.; Serradilla, M.J.; Martín, A. Selection and application of antifungal VOCs-producing yeasts as biocontrol agents of grey mould in fruits. Food Microbial. 2020, 92, 103556. [Google Scholar] [CrossRef] [PubMed]
- Masoud, W.; Poll, L.; Jakobsen, M. Influence of volatile compounds produced by yeasts predominant during processing of Coffea arabica in East Africa on growth and ochratoxin A (OTA) production by Aspergillus ochraceus. Yeast 2005, 22, 1133–1142. [Google Scholar] [CrossRef] [PubMed]
- Calvo, H.; Mendiara, I.; Arias, E.; Gracia, A.P.; Blanco, D.; Venturini, M.E. Antifungal activity of the volatile organic compounds produced by Bacillus velezensis strains against postharvest fungal pathogens. Postharvest Biol. Technol. 2020, 166, 111208. [Google Scholar] [CrossRef]
- Zhao, X.; Zhou, J.; Tian, R.; Liu, Y. Microbial volatile organic compounds: Antifungal mechanisms, applications, and challenges. Front. Microbiol. 2022, 13, 922450. [Google Scholar] [CrossRef] [PubMed]
- Di Francesco, A.; Ugolini, L.; Lazzeri, L.; Mari, M. Production of volatile organic compounds by Aureobasidium pullulans as a potential mechanism of action against post-harvest fruit pathogens. Biol. Control 2015, 81, 8–14. [Google Scholar] [CrossRef]
- Yalage Don, S.M.; Schmidtke, L.M.; Gambetta, J.M.; Steel, C.C. Aureobasidium pullulans volatilome identified by a novel, quantitative approach employing SPME-GC-MS, suppressed Botrytis cinerea and Alternaria alternata in vitro. Sci. Rep. 2020, 10, 4498. [Google Scholar] [CrossRef] [PubMed]
- Guo, H.; Qin, X.; Wu, Y.; Yu, W.; Liu, J.; Xi, Y.; Dou, G.; Wang, L.; Xiao, H. Biocontrol of grey mould of cherry tomatoes with the volatile organic monomer from Hanseniaspora uvarum, trans-cinnamaldehyde. Food Bioproc. Tech. 2019, 12, 1809–1820. [Google Scholar] [CrossRef]
- Huang, R.; Li, G.Q.; Zhang, J.; Yang, L.; Che, H.J.; Jiang, D.H.; Huang, H.C. Control of post-harvest Botrytis fruit rot of strawberry by volatile organic compounds of Candida intermedia. Phytopathology 2011, 101, 859–869. [Google Scholar] [CrossRef] [PubMed]
- Huang, R.; Che, H.J.; Zhang, J.; Yang, L.; Jiang, D.H.; Li, G.Q. Evaluation of Sporidiobolus pararoseus strain YCXT3 as biocontrol agent of Botrytis cinerea on post-harvest strawberry fruits. Biol. Control 2012, 62, 53–63. [Google Scholar] [CrossRef]
- Oro, L.; Feliziani, E.; Ciani, M.; Romanazzi, G.; Comitini, F. Volatile organic compounds from Wickerhamomyces anomalus, Metschnikowia pulcherrima and Saccharomyces cerevisiae inhibit growth of decay causing fungi and control postharvest diseases of strawberries. Int. J. Food Microbiol. 2018, 265, 18–22. [Google Scholar] [CrossRef] [PubMed]
- Di Francesco, A.; Zajc, J.; Gunde-Cimerman, N.; Aprea, E.; Gasperi, F.; Placì, N.; Caruso, F.; Baraldi, E. Bioactivity of volatile organic compounds by Aureobasidium species against grey mould of tomato and table grape World. J. Microbiol. Biotechnol. 2020, 36, 171. [Google Scholar]
- Altieri, M.A. Linking ecologists and traditional farmers in the search for sustainable agriculture. Front. Ecol. Environ. 2004, 2, 35–42. [Google Scholar] [CrossRef]
- Santos, H.; Augusto, C.; Reis, P.; Rego, C.; Figueiredo, A.C.; Fortes, A.M. Volatile metabolism of wine grape Trincadeira: Impact of infection with Botrytis cinerea. Plants 2022, 11, 141. [Google Scholar] [CrossRef]
- Guerrero Prieto, V.M.; Jacobo Cuéllar, J.L.; Parra Quezada, R.Á.; Linares Marrufo, M.I.; Ojeda Barrios, D.L.; Hernández Rodríguez, O.A.; Robles Hernández, L.; Berlanga Reyes, D.I.; Cabanillas Mata, I.J. Botrytis cinerea Pers. in post-harvest apple fruit, control with Candida oleophila Montrocher strains and/or synthetic fungicides. Nov. Sci. 2019, 11, 69–84. [Google Scholar]
- Zajc, J.; Cernosa, A.; Di Francesco, A.; Casteria, R.; De Curtis, F.; Lima, G.; Badri, H.; Jijakli, H.; Ippolito, A.; Gostincar, C.; et al. Characterization of Aureobasidium pullulans isolates selected as biocontrol agents against fruit decay pathogens. Fungal Genom. Biol. 2020, 10, 163. [Google Scholar]
- Zajc, J.; Černoša, A.; Sun, X.; Fang, C.; Gunde-Cimerman, N.; Song, Z.; Gostinčar, C. From glaciers to refrigerators: The population genomics and biocontrol potential of the black yeast Aureobasidium subglaciale. Microbiol. Spectr. 2022, 10, 01455-22. [Google Scholar] [CrossRef] [PubMed]

| Yeast Code | Species Name | Starch | Cellulase | Protease | Glucosidase | Chitinase | Pectinase | Lipase | β-1,3 Glucanase |
|---|---|---|---|---|---|---|---|---|---|
| Y6 | Aureobasidium melanogenum | + * | + | + | + | + | + | + | + |
| Y11 | Debaryomyces hansenii | − | − | − | − | − | − | + | − |
| Y17 | Hanseniaspora occidentalis | − | − | − | − | − | − | + | − |
| Y24 | Meyerozyma guilliermondii | − | − | − | − | − | − | + | − |
| Y35 | Rhodotorula dairenensis | − | − | + | − | − | − | + | + |
| Y39 | M. guilliermondii | − | − | − | − | − | − | + | − |
| Y63 | Suhomyces pyralidae | + | + | + | − | − | − | + | + |
| Y64 | Pichia kluyveri | − | − | − | − | − | − | + | − |
| Y65 | M. guilliermondii | − | − | + | − | − | − | + | + |
| Y74 | Torulaspora delbrueckii | − | − | − | − | − | − | + | + |
| Y75 | Saccharomyces cerevisiae | − | − | − | − | − | − | + | − |
| Y83 | Brettanomyces bruxellensis | − | − | − | − | − | − | + | − |
| Y84 | D. hansenii | − | − | − | − | − | − | + | − |
| Y88 | M. guilliermondii | + | + | + | − | − | − | + | + |
| Y89 | Zygoascus hellenicus | + | + | + | − | − | − | + | + |
| Y91 | Zygosaccharomyces rouxii | − | − | − | − | − | − | + | − |
| Y92 | Z. rouxii | − | − | − | − | − | − | + | − |
| Y93 | Z. microellipsoides | − | − | − | − | − | − | + | − |
| Y95 | Z. florentinus | − | − | − | − | − | − | + | − |
| Y96 | Z. fermentati | − | − | − | − | − | − | + | − |
| Y97 | Z. bisporus | − | − | − | − | − | − | + | − |
| Y102 | Starmerella magnoliae | − | − | − | − | − | − | + | − |
| Y103 | Saccharromyces cerevisiae | − | − | − | − | − | − | + | − |
| Yeast Code | Species Name | Origin |
|---|---|---|
| Y6 | Aureobasidium melanogenum | Jaboticaba fruit |
| Y63 | Suhomyces pyralidae | Shiraz wine fermentation |
| Y64 | Pichia kluyveri | Shiraz wine fermentation |
| Y88 | Meyerozyma guilliermondii | Apple |
| Y89 | Zygoascus hellenicus | Apple |
| Treatment | Description |
|---|---|
| Treatment 1 | Sterile distilled water (Control) |
| Treatment 2 | Botrytis cinerea B05.10 |
| Treatment 3 | B. cinerea IWBT-FF1 |
| Treatment 4 | B. cinerea PPRI 30807 |
| Treatment 5 | B. cinerea B05.10 and Suhomyces pyralidae Y63 |
| Treatment 6 | B. cinerea IWBT-FF1 and S. pyralidae Y63 |
| Treatment 7 | B. cinerea PPRI 30807 and S. pyralidae Y63 |
| Treatment 8 | B. cinerea B05.10 and Pichia kluyveri Y64 |
| Treatment 9 | B. cinerea IWBT-FF1 and P. kluyveri Y64 |
| Treatment 10 | B. cinerea PPRI 30807 and P. kluyveri Y64 |
| Treatment 11 | B. cinerea B05.10 and Aureobasidium melanogenum Y6 |
| Treatment 12 | B. cinerea IWBT-FF1 and A. melanogenum Y6 |
| Treatment 13 | B. cinerea PPRI 30807 and A. melanogenum Y6 |
| Treatment 14 | B. cinerea B05.10 and Captan |
| Treatment 15 | B. cinerea IWBT-FF1 and Captan |
| Treatment 16 | B. cinerea PPRI 30807 and Captan |
| VOCs | B. cinerea | P. kluyveri | P. kluyveri and B. cinerea | S. pyralidae | S. pyralidae and B. cinerea |
|---|---|---|---|---|---|
| Average Area Ratio | |||||
| Isobutanol | ND * | 0.006 | ND | 0.009 | 0.012 |
| Isoamyl acetate | ND | 2.489 | ND | 0.001 | 0.002 |
| Isoamyl alcohol | 0.006 | 0.136 | 0.040 | 0.140 | 0.135 |
| 2-Phenethyl acetate | 0.004 | 3.207 | 1.325 | 0.002 | 0.004 |
| 2-Phenylethanol | 0.005 | 0.155 | 0.034 | 0.021 | 0.019 |
| γ-Decanolactone | ND | ND | ND | 0.008 | 0.003 |
| Methyl palmitate | 0.004 | 0.012 | 0.001 | 0.001 | 0.001 |
Disclaimer/Publisher’s Note: The statements, opinions and data contained in all publications are solely those of the individual author(s) and contributor(s) and not of MDPI and/or the editor(s). MDPI and/or the editor(s) disclaim responsibility for any injury to people or property resulting from any ideas, methods, instructions or products referred to in the content. |
© 2025 by the authors. Licensee MDPI, Basel, Switzerland. This article is an open access article distributed under the terms and conditions of the Creative Commons Attribution (CC BY) license (https://creativecommons.org/licenses/by/4.0/).
Share and Cite
Gomomo, Z.; Fanadzo, M.; Mewa-Ngongang, M.; Chidi, B.S.; Hoff, J.W.; Rijst, M.v.d.; Mokwena, L.; Setati, M.E.; du Plessis, H.W. The Use of Specific Non-Saccharomyces Yeasts as Sustainable Biocontrol Solutions Against Botrytis cinerea on Apples and Strawberries. J. Fungi 2025, 11, 26. https://doi.org/10.3390/jof11010026
Gomomo Z, Fanadzo M, Mewa-Ngongang M, Chidi BS, Hoff JW, Rijst Mvd, Mokwena L, Setati ME, du Plessis HW. The Use of Specific Non-Saccharomyces Yeasts as Sustainable Biocontrol Solutions Against Botrytis cinerea on Apples and Strawberries. Journal of Fungi. 2025; 11(1):26. https://doi.org/10.3390/jof11010026
Chicago/Turabian StyleGomomo, Zukisani, Morris Fanadzo, Maxwell Mewa-Ngongang, Boredi Silas Chidi, Justin Wallace Hoff, Marieta van der Rijst, Lucky Mokwena, Mathabatha Evodia Setati, and Heinrich Wilbur du Plessis. 2025. "The Use of Specific Non-Saccharomyces Yeasts as Sustainable Biocontrol Solutions Against Botrytis cinerea on Apples and Strawberries" Journal of Fungi 11, no. 1: 26. https://doi.org/10.3390/jof11010026
APA StyleGomomo, Z., Fanadzo, M., Mewa-Ngongang, M., Chidi, B. S., Hoff, J. W., Rijst, M. v. d., Mokwena, L., Setati, M. E., & du Plessis, H. W. (2025). The Use of Specific Non-Saccharomyces Yeasts as Sustainable Biocontrol Solutions Against Botrytis cinerea on Apples and Strawberries. Journal of Fungi, 11(1), 26. https://doi.org/10.3390/jof11010026

